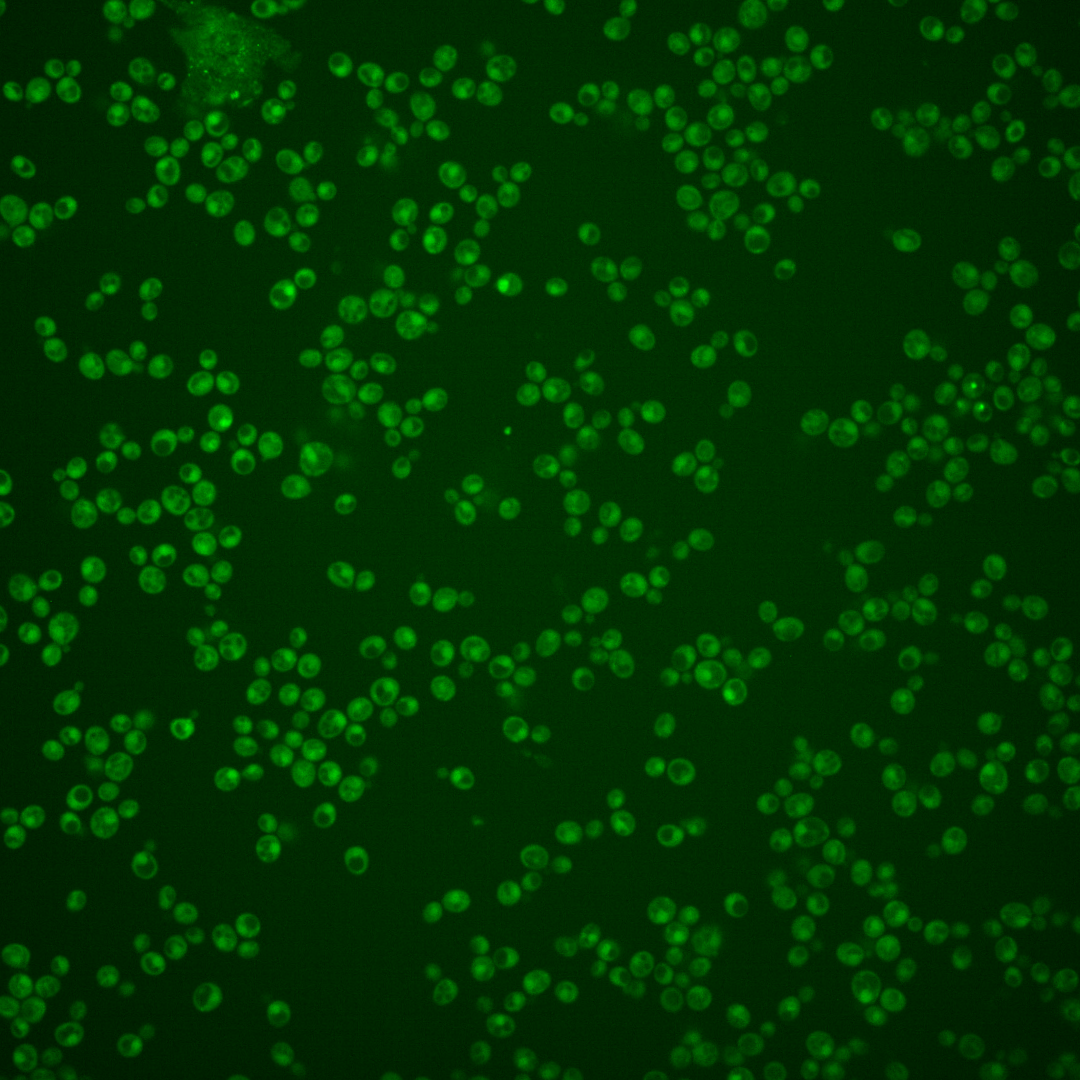
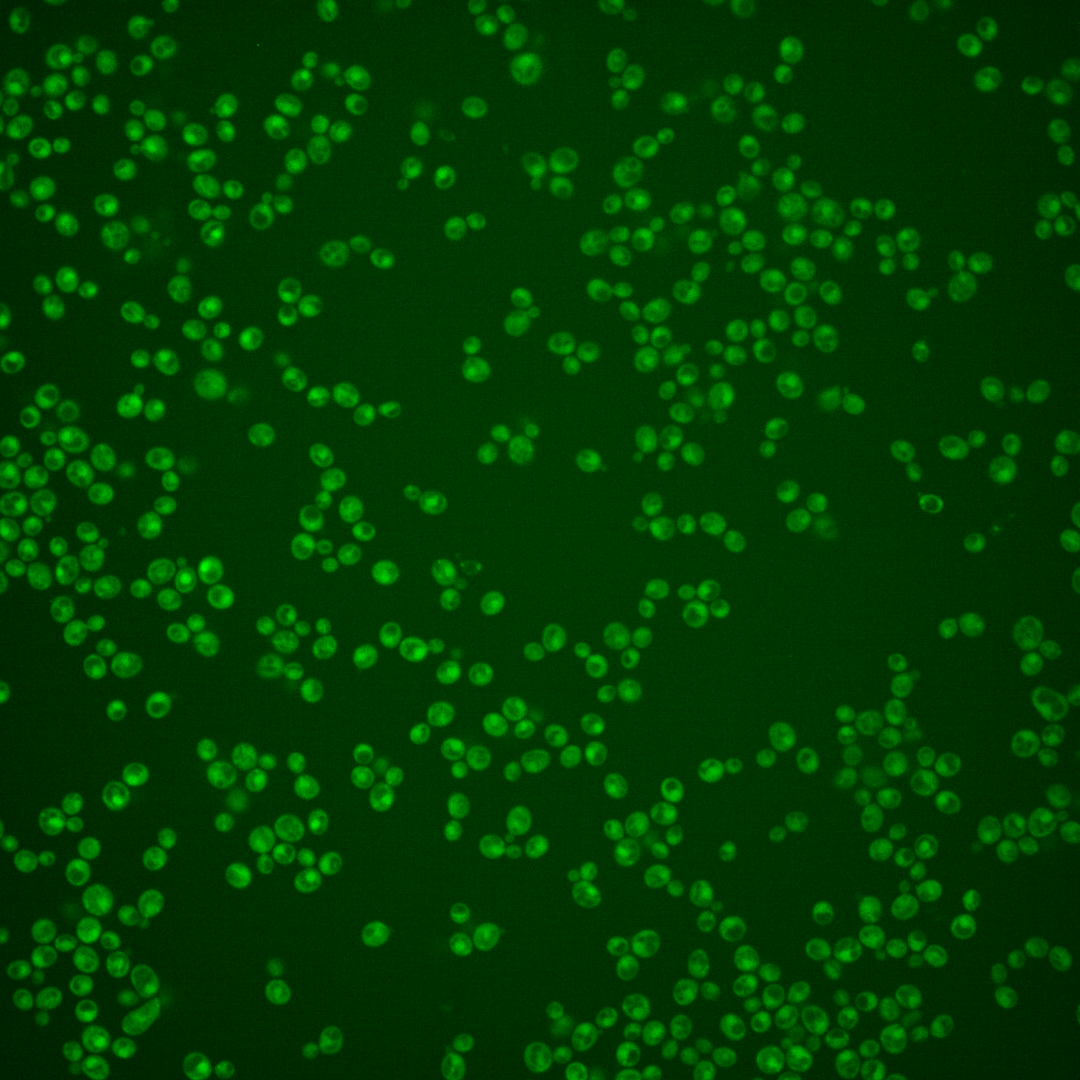

| ORF | |
|---|---|
| Human Ortholog | |
| Description | Putative protein of unknown function; green fluorescent protein (GFP)-fusion protein localizes to both the cytoplasm and the nucleus |
Micrographs




















































































Sub-cellular Localization
Yeast GFP Assignment
Protein Abundance
Localization Change
External localization resources
| ensLOC | DeepLoc | |||||||||||||||||||||||
|---|---|---|---|---|---|---|---|---|---|---|---|---|---|---|---|---|---|---|---|---|---|---|---|---|
| Localization | WT1 | WT2 | WT3 | RAP60 | RAP140 | RAP220 | RAP300 | RAP380 | RAP460 | RAP540 | RAP620 | RAP700 | HU80 | HU120 | HU160 | rpd3Δ_1 | rpd3Δ_2 | rpd3Δ_3 | WT1 | WT2 | WT3 | AF100 | AF140 | AF180 |
| Cortical Patches | 0 | 0 | 1 | 0 | 0 | 0 | – | 0 | 0 | 0 | 0 | 0 | 0 | 0 | 0 | 0 | 0 | 0 | 2 | 0 | 0 | 0 | 0 | 1 |
| Bud | 1 | 0 | 2 | 0 | 0 | 2 | – | 3 | 1 | 5 | 3 | 3 | 0 | 0 | 0 | 0 | 0 | 0 | 8 | 1 | 1 | 1 | 6 | 9 |
| Bud Neck | 0 | 0 | 1 | 0 | 0 | 0 | – | 0 | 0 | 0 | 0 | 0 | 0 | 0 | 1 | 0 | 0 | 0 | 3 | 0 | 2 | 0 | 3 | 7 |
| Bud Site | 0 | 0 | 0 | 0 | 0 | 0 | – | 4 | 0 | 1 | 1 | 2 | 0 | 0 | 0 | 0 | 0 | 0 | – | – | – | – | – | – |
| Cell Periphery | 1 | 0 | 0 | 0 | 0 | 0 | – | 0 | 0 | 0 | 0 | 0 | 0 | 1 | 2 | 1 | 0 | 1 | 0 | 0 | 0 | 0 | 0 | 0 |
| Cytoplasm | 258 | 12 | 46 | 17 | 67 | 98 | – | 71 | 43 | 37 | 51 | 47 | 153 | 311 | 370 | 70 | 24 | 43 | 274 | 35 | 66 | 115 | 131 | 137 |
| Endoplasmic Reticulum | 3 | 1 | 0 | 1 | 0 | 0 | – | 0 | 0 | 0 | 1 | 0 | 0 | 3 | 3 | 7 | 3 | 3 | 1 | 0 | 0 | 0 | 0 | 0 |
| Endosome | 9 | 0 | 0 | 0 | 6 | 0 | – | 1 | 0 | 1 | 0 | 0 | 0 | 7 | 2 | 7 | 1 | 6 | 5 | 0 | 1 | 0 | 3 | 1 |
| Golgi | 0 | 0 | 0 | 0 | 0 | 0 | – | 0 | 0 | 1 | 0 | 0 | 0 | 0 | 0 | 2 | 0 | 1 | 2 | 0 | 0 | 1 | 1 | 2 |
| Mitochondria | 31 | 1 | 31 | 26 | 15 | 119 | – | 178 | 117 | 147 | 186 | 177 | 1 | 7 | 3 | 3 | 1 | 7 | 5 | 0 | 9 | 4 | 3 | 2 |
| Nucleus | 8 | 1 | 4 | 0 | 12 | 31 | – | 83 | 44 | 58 | 72 | 64 | 8 | 5 | 0 | 13 | 4 | 11 | 69 | 20 | 19 | 31 | 31 | 35 |
| Nuclear Periphery | 0 | 0 | 0 | 1 | 0 | 0 | – | 3 | 0 | 0 | 1 | 3 | 0 | 0 | 0 | 0 | 0 | 1 | 1 | 0 | 0 | 0 | 0 | 0 |
| Nucleolus | 1 | 1 | 0 | 1 | 0 | 1 | – | 0 | 0 | 3 | 0 | 0 | 0 | 0 | 0 | 0 | 0 | 1 | 0 | 0 | 0 | 0 | 0 | 0 |
| Peroxisomes | 0 | 0 | 0 | 0 | 0 | 0 | – | 0 | 0 | 0 | 0 | 0 | 0 | 0 | 0 | 0 | 0 | 0 | 0 | 0 | 0 | 0 | 0 | 0 |
| SpindlePole | 1 | 1 | 0 | 0 | 0 | 0 | – | 0 | 0 | 0 | 0 | 0 | 0 | 0 | 0 | 0 | 0 | 0 | 12 | 1 | 1 | 3 | 6 | 4 |
| Vac/Vac Membrane | 140 | 11 | 14 | 8 | 31 | 43 | – | 58 | 22 | 21 | 24 | 24 | 65 | 73 | 47 | 50 | 23 | 45 | 61 | 16 | 27 | 30 | 41 | 41 |
| Unique Cell Count | 386 | 24 | 81 | 43 | 115 | 228 | 294 | 168 | 207 | 252 | 236 | 199 | 368 | 409 | 130 | 49 | 100 | 460 | 78 | 136 | 195 | 237 | 248 | |
| Labelled Cell Count | 453 | 28 | 99 | 54 | 131 | 294 | 401 | 227 | 274 | 339 | 320 | 227 | 407 | 428 | 153 | 56 | 119 | 460 | 78 | 136 | 195 | 237 | 248 | |
Yeast GFP Assignment
Protein Abundance
| Screen | WT1 | WT2 | WT3 | RAP60 | RAP140 | RAP220 | RAP300 | RAP380 | RAP460 | RAP540 | RAP620 | RAP700 | HU80 | HU120 | HU160 | rpd3Δ_1 | rpd3Δ_2 | rpd3Δ_3 | AF100 | AF140 | AF180 |
|---|---|---|---|---|---|---|---|---|---|---|---|---|---|---|---|---|---|---|---|---|---|
| Mean Cell GFP Intensity (1e-4) | 4.3 | 4.8 | 3.6 | 4.2 | 4.7 | 3.7 | – | 3.9 | 3.5 | 3.9 | 3.6 | 3.3 | 4.8 | 5.1 | 4.8 | 6.8 | 6.8 | 6.7 | 4.7 | 5.3 | 5.4 |
| Std Deviation (1e-4) | 0.6 | 0.6 | 0.6 | 2.0 | 1.5 | 1.5 | – | 1.4 | 1.3 | 3.2 | 1.2 | 0.7 | 0.7 | 1.0 | 0.9 | 1.5 | 1.9 | 1.9 | 0.8 | 1.5 | 1.4 |
| Intensity Change (Log2) | – | – | – | 0.23 | 0.39 | 0.06 | – | 0.14 | -0.03 | 0.13 | 0.03 | -0.08 | 0.44 | 0.52 | 0.45 | 0.94 | 0.95 | 0.91 | 0.39 | 0.58 | 0.59 |
Localization Change
| Localization | RAP60 | RAP140 | RAP220 | RAP300 | RAP380 | RAP460 | RAP540 | RAP620 | RAP700 | HU80 | HU120 | HU160 | rpd3Δ_1 | rpd3Δ_2 | rpd3Δ_3 |
|---|---|---|---|---|---|---|---|---|---|---|---|---|---|---|---|
| Actin | – | – | – | – | – | – | – | – | – | – | – | – | – | – | – |
| Bud | – | – | – | – | – | – | – | – | – | – | – | – | 0 | 0 | 0 |
| Bud Neck | – | – | – | – | – | – | – | – | – | – | – | – | 0 | 0 | 0 |
| Bud Site | – | – | – | – | – | – | – | – | – | – | – | – | 0 | 0 | 0 |
| Cell Periphery | – | – | – | – | – | – | – | – | – | – | – | – | 0 | 0 | 0 |
| Cyto | – | – | – | – | – | – | – | – | – | – | – | – | – | – | – |
| Endoplasmic Reticulum | – | – | – | – | – | – | – | – | – | – | – | – | 0 | 0 | 0 |
| Endosome | – | – | – | – | – | – | – | – | – | – | – | – | 0 | 0 | 0 |
| Golgi | – | – | – | – | – | – | – | – | – | – | – | – | 0 | 0 | 0 |
| Mitochondria | – | – | – | – | – | – | – | – | – | – | – | – | 0 | 0 | 0 |
| Nuclear Periphery | – | – | – | – | – | – | – | – | – | – | – | – | 0 | 0 | 0 |
| Nuc | – | – | – | – | – | – | – | – | – | – | – | – | – | – | – |
| Nucleolus | – | – | – | – | – | – | – | – | – | – | – | – | 0 | 0 | 0 |
| Peroxisomes | – | – | – | – | – | – | – | – | – | – | – | – | 0 | 0 | 0 |
| SpindlePole | – | – | – | – | – | – | – | – | – | – | – | – | 0 | 0 | 0 |
| Vac | – | – | – | – | – | – | – | – | – | – | – | – | – | – | – |
| Cortical Patches | – | – | – | – | – | – | – | – | – | – | – | – | 0 | 0 | 0 |
| Cytoplasm | – | – | – | – | – | – | – | – | – | – | – | – | 0 | 0 | 0 |
| Nucleus | – | – | – | – | – | – | – | – | – | – | – | – | 0 | 0 | 0 |
| Vacuole | – | – | – | – | – | – | – | – | – | – | – | – | 3.3 | 3.6 | 4.0 |
External localization resources
Images






























Protein Concentration and Protein Localization Data
| R1 | R2 | R3 | ||||||||||||||||
|---|---|---|---|---|---|---|---|---|---|---|---|---|---|---|---|---|---|---|
| G1 Pre-START | G1 Post-START | S/G2 | Metaphase | Anaphase | Telophase | G1 Pre-START | G1 Post-START | S/G2 | Metaphase | Anaphase | Telophase | G1 Pre-START | G1 Post-START | S/G2 | Metaphase | Anaphase | Telophase | |
| Concentration | -0.6677 | -0.3774 | -0.3955 | -0.5624 | -0.4102 | -0.3803 | 3.7872 | 1.8376 | 2.7542 | -0.9114 | -0.9023 | 3.1179 | 0.9023 | 0.8451 | 0.633 | 0.625 | 0.7408 | 0.8609 |
| Actin | 0.0326 | 0.0001 | 0.0022 | 0.0131 | 0.0116 | 0.0004 | 0.0271 | 0.0004 | 0.0033 | 0.0076 | 0.0008 | 0.0009 | 0.0318 | 0.0001 | 0.0117 | 0.0004 | 0.0553 | 0.0137 |
| Bud | 0.0003 | 0.0001 | 0.001 | 0.0001 | 0.0003 | 0.0001 | 0.0029 | 0.0098 | 0.001 | 0.001 | 0.0011 | 0.0005 | 0.0006 | 0.0002 | 0 | 0.0001 | 0.0008 | 0.0004 |
| Bud Neck | 0.0013 | 0.0018 | 0.0026 | 0.0002 | 0.0001 | 0.0026 | 0.0078 | 0.0002 | 0.0003 | 0.0004 | 0.0005 | 0.002 | 0.0008 | 0.0001 | 0.0001 | 0.0002 | 0.0003 | 0.0018 |
| Bud Periphery | 0.0004 | 0.0002 | 0.0013 | 0.0002 | 0.0001 | 0.0001 | 0.0032 | 0.0027 | 0.0003 | 0.0007 | 0.0012 | 0.0005 | 0.0013 | 0.0003 | 0 | 0.0001 | 0.0017 | 0.0006 |
| Bud Site | 0.0028 | 0.0008 | 0.0009 | 0.0003 | 0.0002 | 0.0002 | 0.0117 | 0.0073 | 0.0009 | 0.002 | 0.0015 | 0.0019 | 0.0019 | 0.0005 | 0.0001 | 0 | 0.0024 | 0.0005 |
| Cell Periphery | 0.0002 | 0.0001 | 0.0001 | 0.0001 | 0 | 0 | 0.001 | 0.0005 | 0.0003 | 0.0001 | 0.0001 | 0.0001 | 0.0003 | 0.0001 | 0 | 0 | 0.0001 | 0.0001 |
| Cytoplasm | 0.1317 | 0.2204 | 0.2469 | 0.2111 | 0.1553 | 0.3566 | 0.1968 | 0.3297 | 0.2863 | 0.1943 | 0.2432 | 0.3716 | 0.1198 | 0.2189 | 0.158 | 0.223 | 0.1531 | 0.2514 |
| Cytoplasmic Foci | 0.0341 | 0.0048 | 0.016 | 0.0041 | 0.0294 | 0.0178 | 0.0336 | 0.0071 | 0.0165 | 0.0288 | 0.0183 | 0.0242 | 0.0498 | 0.0044 | 0.0056 | 0.0032 | 0.0038 | 0.0074 |
| Eisosomes | 0.0007 | 0.0001 | 0.0001 | 0.0006 | 0.0001 | 0 | 0.0004 | 0.0001 | 0.0002 | 0.0001 | 0.0001 | 0.0001 | 0.0007 | 0.0001 | 0.0005 | 0.0001 | 0.0005 | 0.0001 |
| Endoplasmic Reticulum | 0.0037 | 0.0023 | 0.0036 | 0.0023 | 0.0013 | 0.0019 | 0.0069 | 0.0032 | 0.003 | 0.0048 | 0.0043 | 0.0046 | 0.0084 | 0.002 | 0.001 | 0.007 | 0.0024 | 0.0052 |
| Endosome | 0.0202 | 0.0071 | 0.0076 | 0.009 | 0.0077 | 0.0053 | 0.0318 | 0.0028 | 0.0049 | 0.0104 | 0.0812 | 0.0102 | 0.0158 | 0.0012 | 0.0009 | 0.0029 | 0.0062 | 0.0071 |
| Golgi | 0.0071 | 0.0009 | 0.0029 | 0.0031 | 0.0137 | 0.0016 | 0.0097 | 0.0002 | 0.0007 | 0.0104 | 0.0316 | 0.0013 | 0.0047 | 0.0001 | 0.0006 | 0.0001 | 0.0068 | 0.0028 |
| Lipid Particles | 0.0159 | 0.0004 | 0.0018 | 0.0247 | 0.0146 | 0.0006 | 0.0125 | 0.0007 | 0.0019 | 0.0197 | 0.0246 | 0.001 | 0.0202 | 0.0002 | 0.0005 | 0.0003 | 0.0073 | 0.0023 |
| Mitochondria | 0.0037 | 0.0003 | 0.0101 | 0.0029 | 0.004 | 0.001 | 0.0066 | 0.0004 | 0.0012 | 0.0099 | 0.0108 | 0.0013 | 0.0042 | 0.0004 | 0.0005 | 0.001 | 0.017 | 0.0016 |
| None | 0.6867 | 0.7148 | 0.6334 | 0.6795 | 0.7344 | 0.5306 | 0.5628 | 0.5861 | 0.6077 | 0.6372 | 0.4715 | 0.4626 | 0.6107 | 0.6904 | 0.7942 | 0.7216 | 0.7275 | 0.5955 |
| Nuclear Periphery | 0.0135 | 0.0025 | 0.0053 | 0.0162 | 0.0013 | 0.0036 | 0.015 | 0.0045 | 0.0048 | 0.0132 | 0.0095 | 0.0093 | 0.0133 | 0.0036 | 0.0016 | 0.0067 | 0.0052 | 0.0089 |
| Nucleolus | 0.0013 | 0.0005 | 0.0005 | 0.0016 | 0.0002 | 0.0008 | 0.0018 | 0.0007 | 0.0012 | 0.001 | 0.0005 | 0.0013 | 0.0012 | 0.0008 | 0.0004 | 0.0009 | 0.0003 | 0.0008 |
| Nucleus | 0.0073 | 0.0336 | 0.0469 | 0.0132 | 0.0048 | 0.065 | 0.0367 | 0.0334 | 0.045 | 0.0264 | 0.0661 | 0.0876 | 0.0397 | 0.0671 | 0.0208 | 0.0202 | 0.0027 | 0.0855 |
| Peroxisomes | 0.0149 | 0.0001 | 0.0053 | 0.0051 | 0.0106 | 0.0018 | 0.0098 | 0.0003 | 0.0067 | 0.0119 | 0.009 | 0.0003 | 0.0434 | 0.0002 | 0.0003 | 0.0002 | 0.0031 | 0.0016 |
| Punctate Nuclear | 0.0178 | 0.0034 | 0.0084 | 0.0104 | 0.0098 | 0.009 | 0.0051 | 0.006 | 0.0105 | 0.0168 | 0.008 | 0.0147 | 0.0281 | 0.0079 | 0.0027 | 0.0107 | 0.0019 | 0.0108 |
| Vacuole | 0.003 | 0.0053 | 0.0022 | 0.0007 | 0.0004 | 0.0008 | 0.0134 | 0.0034 | 0.0026 | 0.0023 | 0.011 | 0.0031 | 0.0023 | 0.0013 | 0.0004 | 0.001 | 0.0006 | 0.0015 |
| Vacuole Periphery | 0.001 | 0.0003 | 0.0011 | 0.0013 | 0.0002 | 0.0002 | 0.0035 | 0.0004 | 0.0006 | 0.0011 | 0.0051 | 0.001 | 0.0012 | 0.0002 | 0.0001 | 0.0005 | 0.0009 | 0.0005 |
Sequencing Data
| R1 | R2 | |||||||||
|---|---|---|---|---|---|---|---|---|---|---|
| G1 Post-START | S/G2 | Metaphase | Anaphase | Telophase | G1 Post-START | S/G2 | Metaphase | Anaphase | Telophase | |
| Gene Expression | 8.1994 | 10.4711 | 13.986 | 10.9444 | 13.6683 | 9.3656 | 10.5873 | 16.4351 | 17.158 | 14.1986 |
| Translational Efficiency | 0.901 | 0.6715 | 0.5973 | 0.7044 | 0.3555 | 1.1842 | 0.8369 | 0.4768 | 0.3235 | 0.3859 |
Hit Data
| Dataset | Hit |
|---|---|
| Protein Concentration | ✘ |
| Protein Localization | ✘ |
| Gene Expression | ✘ |
| Translational Efficiency | ✘ |
Endocytosis
| Temp | Actin Patch (Sac6-tdTomato) | Cortical Patch (Sla1-GFP) | Late Endosome (Snf7-GFP) | Vacuole (Vph1-GFP) |
|---|---|---|---|---|
| 37℃ | ||||
| RT |
Cell Cycle Omics
CYCLoPs (Ypl071c-GFP)
| Gene / Allele | Actin Patch (Sac6-tdTomato) | Cortical Patch (Sla1-GFP) | Late Endosome (Snf7-GFP) | Vacuole (Sac6-tdTomato) |
|---|
| Gene | Images |
|---|
| Gene | Images |
|---|
Images are not yet available
Images are not yet available